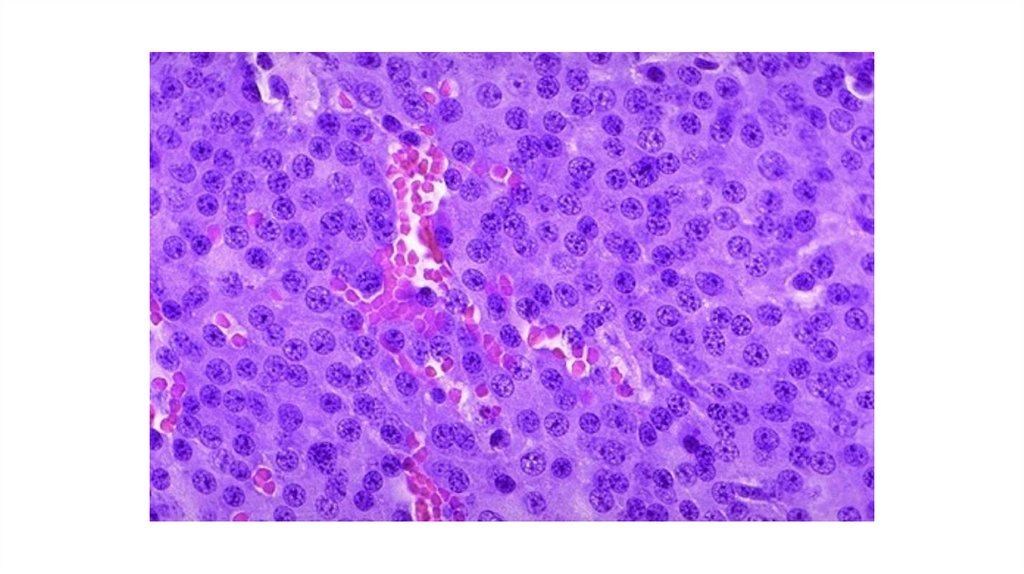

Похожие презентации:
микро 3 коллок расшифр
1.
2.
3.
4. Диффузный токсический зоб, Базедов зоб
5. Коллоидный зоб (струма)
6.
Атрофияпаренхимы ЩЖ
Вторичн фолликул
с герминативным
центром
7.
8. Лимфатический узел при лимфоме Ходжкина
КлеткаХоджкина
Клетка
РидБерезовскогоШтернберга
9. Печень при лимфоцитарном лейкозе
Желчн.проток
артерия
Вена
10. Печень при миелолейкозе
11. Пигментный невус
12. Меланома
13. Эндоцервикоз шейки матки
14.
Децидуальнаятрансформация
слизистой
оболочки
Ворсины
хориона
15.
16.
Элементыцитотрофоб
ласта
Элементы
синцитиотр
офобласта